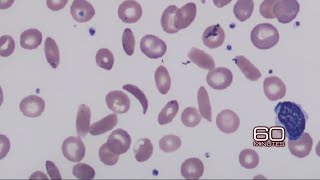

Researchers inch closer to possible cure for sickle cell anemia video
Online izle ve mp4 mp3 formatlarinda yukle

Videonun muddeti: 1:41
Researchers inch closer to possible cure for sickle cell anemia videosu mp4 ve mp3 yuklemek ucun hazirdir
Diqqet! Siz Mp4 yukle ve ya Mp3 yukle duymesine basdiqdan sonra eger sistem sizi reklam sehifesine atarsa o zaman derhal geri qayidib emeliyyati tekrar edin ve faylin yuklemek ucun hazir olmasini gozleyin
Videodan Mp4 Yukle
Videodan Mp3 Yukle-1
Videodan Mp3 Yukle-2
Oxshar Axtarishlar
 Researchers inch closer to possible cure for sickle cell anemia
Researchers inch closer to possible cure for sickle cell anemia Researchers discover breakthrough in quest to cure sickle cell anemia
Researchers discover breakthrough in quest to cure sickle cell anemia Gene therapy scientists move closer to 'cure' for Sickle Cell Disease
Gene therapy scientists move closer to 'cure' for Sickle Cell Disease Scientists edge closer to 'cure' for sickle cell
Scientists edge closer to 'cure' for sickle cell Doctored DNA: Gene-editing a possible cure for Sickle Cell Anemia
Doctored DNA: Gene-editing a possible cure for Sickle Cell Anemia How Far We’ve come: Clinical Research and Sickle Cell Disease
How Far We’ve come: Clinical Research and Sickle Cell Disease Researchers Develop Effective Treatment for Sickle Cell Anemia
Researchers Develop Effective Treatment for Sickle Cell Anemia Defeating Sickle Cell Disease with Stem Cells + Gene Therapy: Stem Cells in Your Face, Episode 2
Defeating Sickle Cell Disease with Stem Cells + Gene Therapy: Stem Cells in Your Face, Episode 2 Sickle Cell Anemia: Stem Cell Gene Therapy - Donald Kohn
Sickle Cell Anemia: Stem Cell Gene Therapy - Donald Kohn
Video Mp4 Mp3Azwap.Biz
Azwap.Biz 2021-2023

Researchers inch closer to possible cure for sickle cell anemia
Researchers inch closer to possible cure for sickle cell anemia Researchers discover breakthrough in quest to cure sickle cell anemia
Researchers discover breakthrough in quest to cure sickle cell anemia Gene therapy scientists move closer to 'cure' for Sickle Cell Disease
Gene therapy scientists move closer to 'cure' for Sickle Cell Disease Scientists edge closer to 'cure' for sickle cell
Scientists edge closer to 'cure' for sickle cell Doctored DNA: Gene-editing a possible cure for Sickle Cell Anemia
Doctored DNA: Gene-editing a possible cure for Sickle Cell Anemia How Far We’ve come: Clinical Research and Sickle Cell Disease
How Far We’ve come: Clinical Research and Sickle Cell Disease Researchers Develop Effective Treatment for Sickle Cell Anemia
Researchers Develop Effective Treatment for Sickle Cell Anemia Defeating Sickle Cell Disease with Stem Cells + Gene Therapy: Stem Cells in Your Face, Episode 2
Defeating Sickle Cell Disease with Stem Cells + Gene Therapy: Stem Cells in Your Face, Episode 2 Sickle Cell Anemia: Stem Cell Gene Therapy - Donald Kohn
Sickle Cell Anemia: Stem Cell Gene Therapy - Donald Kohn